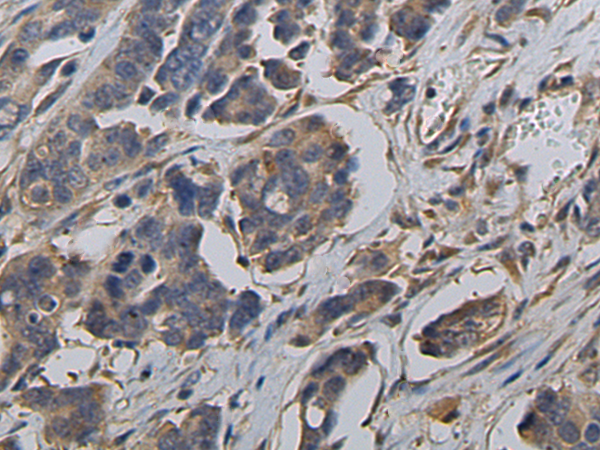

|
Background: |
This gene encodes a member of the sorting nexin family. Members of this family contain a phox (PX) domain, which is a phosphoinositide binding domain, and are involved in intracellular trafficking. This protein does not contain a coiled coil region, like some family members, but contains a B41 domain. This protein interacts with the cytoplasmic domain of P-selectin, and may function in the intracellular trafficking of P-selectin. Alternative splicing results in multiple transcript variants encoding different isoforms. |
|
Applications: |
ELISA, WB, IHC |
|
Name of antibody: |
SNX17 |
|
Immunogen: |
Fusion protein of human SNX17 |
|
Full name: |
sorting nexin 17 |
|
SwissProt: |
Q15036 |
|
ELISA Recommended dilution: |
5000-10000 |
|
IHC positive control: |
Human colorectal cancer and Human esophagus cancer |
|
IHC Recommend dilution: |
50-200 |
|
WB Predicted band size: |
52 kDa |
|
WB Positive control: |
293T cell lysate |
|
WB Recommended dilution: |
500-2000 |

購物車
幫助
021-54845833/15800441009
